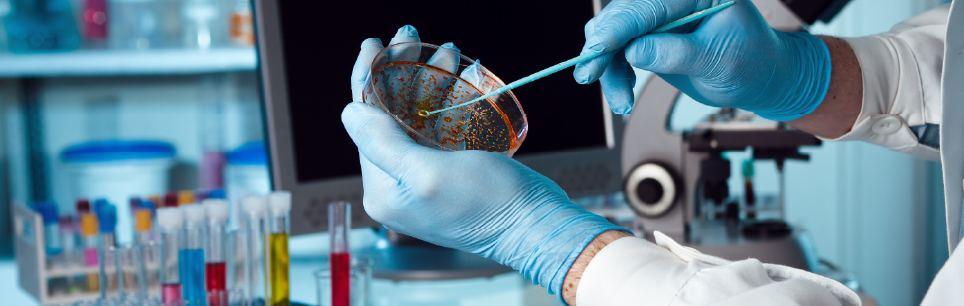

خانه > پاتولوژی (آسیب شناسی)
آزمایش پاتولوژی یکی از روشهای مهم تشخیص بیماریها در پزشکی است. این آزمایش به بررسی نمونههای بافتی یا سلولی از بدن بیمار میپردازد و تغییرات آسیب دیده را تحت میکروسکوپ مشاهده میکند. پاتولوژی (pathology) میتواند نوع، مرحله و شدت بیماری را مشخص کند و به پزشکان در انتخاب روش درمان مناسب کمک کند. طب پاتولوژی در تشخیص بیماریهای مختلف از جمله سرطان، عفونت، التهاب، اختلالات خونی، اختلالات ایمنی و اختلالات ژنتیکی کاربرد دارد.
طبق تعریف پاتولوژی ویکی پدیا، این علم به بررسی اثرات بیماری در بافتهای مختلف بدن میپردازد و اهمیت بالایی در تشخیص بیماریهای مختلف از جمله انواع سرطان دارد. در این مقاله به شما میگوییم که پاتولوژی چیست و آزمایشات پاتولوژی در چه زمینههایی به کار میروند.
آزمایش پاتولوژی یک روش تشخیصی است که با بررسی نمونههای بافتی یا سلولی از بدن، علت یا ماهیت بیماریها را مشخص میکند. در پاتولوژی آزمایشگاه، یک پزشک متخصص نمونهها را با استفاده از میکروسکوپ و روشهای رنگآمیزی مختلف مورد بررسی قرار میدهد و گزارشی از تغییرات ساختاری و عملکردی بافتها و سلولها ارائه میکند.
پاتولوژی و آزمایشگاه به دو دستهی بالینی و تشریحی تقسیم میشود:
تجهیزات آزمایش پاتولوژی از ابزارهایی هستند که برای بررسی و تشخیص بیماریها از طریق مطالعه بافتها و مایعات بدن استفاده میشوند. برخی از این تجهیزات عبارتند از:

روش انجام آزمایش پاتولوژی ممکن است به چند مرحله اصلی نیاز داشته باشد:
مراحل مختلف این آزمایشات بسته به نوع بیماری یا نوع نمونه ممکن است متفاوت باشند. همچنین، تکنیکها و تجهیزات مورد استفاده نیز میتوانند متفاوت باشند بر اساس نوع آزمایش و نوع نمونه.
ایمونوهیستوشیمی (IHC) یکی از روش های مهم و پرکاربرد آزمایش پاتولوژی است که در تشخیص و افتراق بسیاری از بیماری ها، به ویژه سرطان ها، نقش اساسی دارد. این روش بر اساس واکنش آنتی ژن – آنتی بادی که یکی از مبانی ایمونولوژی است، کار می کند. آنتی ژن ها مولکول هایی هستند که توسط سیستم ایمنی بدن به عنوان بیگانه شناخته می شوند و پاسخ ایمنی را القا میکنند.
پاتولوژی و پزشکی قانونی دو رشته مرتبط از علوم پزشکی هستند که در حل مسائل و پرونده های حقوقی و قضایی نقش دارند. پاتولوژی علمی است که با بررسی نمونه های بافتی و سلولی از بدن انسان، علت، ماهیت و پیامدهای بیماری ها و آسیب ها را تشخیص می دهد و با استفاده از روش های مختلفی نمونه ها را مورد آزمایش قرار می دهد و گزارش های پاتولوژیک را تهیه می کند.
پزشکی قانونی از مهارت های پاتولوژی و سایر رشته های پزشکی در مواردی مانند تعیین علت و شیوه مرگ، شناسایی قربانیان و مجرمان جرایم، جمع آوری و تحلیل شواهد فیزیکی و ارائه نظرات و شهادت های کارشناسی در دادگاه ها استفاده میکند.
پاتولوژی و پزشکی قانونی با همکاری و هماهنگی نزدیک با یکدیگر، می توانند در روشن شدن حقیقت و رسیدگی به مسائل و پرونده های حقوقی و قضایی مؤثر باشند.
پاتولوژی یکی از گستردهترین و مهمترین شاخههای پزشکی است که در تشخیص، پیشگیری و درمان بسیاری از بیماریها نقش دارد. امروزه پزشکان با استفاده از خواندن جواب آزمایش پاتولوژی میتوانند طیف وسیعی از بیماریهای مختلف را شناسایی کرده و نسخه درمان آنها را ارائه کنند.
از این رو، آزمایش پاتولوژی برای بررسی بافتها و اندامهای بسیار زیادی در بدن استفاده میشود. در ادامه برخی از آنها را بررسی میکنیم.
لنفوم یک نوع سرطان است که از سلولهای لنفوسیت که سلولهای خونی هستند را تحت تاثیر قرار میدهد. سیستم لنفاوی شامل غدد لنفاوی، طحال، تیموس و مغز استخوان است. لنفوم به دو دسته اصلی تقسیم میشود: لنفوم هاجکین و لنفوم غیرهاجکین.
تشخیص لنفوم با بررسی پاتولوژی نمونههای بافتی از غدد لنفاوی یا سایر اندامهای درگیر انجام میشود.
پاتولوژی لنفوم شامل موارد زیر است:
غدد لنفاوی گرههای کوچکی هستند که در سراسر بدن وجود دارند و مواد مختلفی را از خون فیلتر میکنند. در لنفوم، سلولهای لنفوسیت در غدد لنفاوی بیش از حد رشد میکنند و باعث تورم و درد میشوند. پاتولوژیست با برداشتن نمونهای از غده لنفاوی و مشاهده آن زیر میکروسکوپ، میتواند نوع، مرحله و شدت لنفوم را تعیین کند.
غدد لنفاوی زیر بغل به عنوان یکی از محلهای شایع درگیری لنفوم شناخته میشوند. این غدد مسئول فیلتر کردن مایعات و سلولهای خونی از بازوها، سینه و شکم هستند. در لنفوم، این غدد ممکن است بزرگ و سفت شوند و باعث علائمی مانند درد، تورم، عفونت و تب میشوند. پاتولوژیست با بیوپسی یا برداشتن تکهای از غده لنفاوی زیر بغل، میتواند تشخیص لنفوم را تأیید یا رد کند.
پاتولوژی غدد و پاتولوژی توده گردن بخش مهمی از علم پاتولوژی است. غده چربی یا لیپوم یک توده چربی است که در زیر پوست رشد میکند. این توده معمولا خوش خیم است و علائمی ندارد. اما در برخی موارد، ممکن است لنفوم با غده چربی اشتباه گرفته شود. برای تفکیک این دو، پاتولوژیست با برداشتن نمونهای از توده و بررسی آن زیر میکروسکوپ، میتواند مشخص کند که آیا توده حاوی سلولهای لنفوسیت است یا خیر.
جواب آزمایش پاتولوژی لنفوم میتواند شامل اطلاعاتی مانند نوع و مرحله لنفوم، شدت و گسترش بیماری، وضعیت گیرندههای هورمونی و ژنتیکی و سایر تستهای انجام شده باشد. این گزارش به پزشک کمک میکند تا برنامه درمانی مناسب را برای بیمار تعیین کند.
برای مثال، اگر گزارش نشان دهد که لنفوم هاجکین است، پزشک ممکن است شیمی درمانی یا پرتودرمانی را پیشنهاد کند. اگر گزارش نشان دهد که لنفوم غیرهاجکین است، پزشک ممکن است درمانهای مختلفی را بسته به نوع، مرحله و شدت بیماری تجویز کند.
پاتولوژی کیسه صفرا بررسی میکروسکوپی بافت کیسه صفرا است که به منظور تشخیص بیماریهای مختلف از جمله التهاب، سنگ کیسه صفرا و سرطان انجام میشود. پاتولوژی کیسه صفرا معمولاً بعد از عمل جراحی برداشتن کیسه صفرا (کوله سیستکتومی) انجام میشود.
هدف از انجام آزمایش پاتولوژی بعد از عمل کیسه صفرا این است که نوع و شدت بیماری کیسه صفرا را مشخص کند. برای این منظور، کیسه صفرا یا قسمتی از آن که در طول عمل جراحی برداشته شده است، به آزمایشگاه پاتولوژی فرستاده میشود. پاتولوژیست بافت کیسه صفرا را با میکروسکوپ مورد بررسی قرار میدهد و گزارشی از نتایج خود تهیه میکند.
جواب پاتولوژی صفرا میتواند شامل موارد زیر باشد:
آزمایش پاتولوژی بعد از عمل پروستات یک روش تشخیصی است که در آن بافت خارج شده از غده پروستات توسط یک پاتولوژیست مورد بررسی قرار می گیرد. این آزمایش می تواند نوع، مرحله و شدت سرطان پروستات را مشخص کند. برای انجام پاتولوژی پروستات، نیاز به برداشتن نمونه از پروستات با سوزن یا جراحی است. بعد از عمل، نمونه به آزمایشگاه فرستاده می شود و نتیجه آن معمولاً در یک هفته آماده می شود.
خواندن جواب پاتولوژی پروستات ممکن است کمی پیچیده باشد. اما با توجه به برخی اصطلاحات و مفاهیم، می توانید از وضعیت خود آگاه شوید. برخی از این اصطلاحات عبارتند از:
پاتولوژی غده تیروئید علمی است که به بررسی نمونههای بافتی یا سلولی از غده تیروئید میپردازد. با آزمایش پاتولوژی میتوان به تشخیص بیماریهای مختلف تیروئیدی مانند سرطان، التهاب و… کمک کرد.
پاتولوژی سرطان تیروئید به تشخیص نوع و مرحله سرطان تیروئیدی که در غده تیروئید رشد میکند میپردازد. سرطان تیروئید ممکن است از چهار نوع اصلی باشد:
به بررسی نمونههای بافتی که در طی جراحی تیروئید از غده تیروئید یا گرههای لنفاوی حذف شدهاند، میپردازد. پاتولوژی بعد از عمل تیروئید میتواند به تایید یا رد تشخیص اولیه سرطان تیروئید، تعیین مرحله و گسترش سرطان، شناسایی عوامل پیشبینی و پیشآگهی و تعیین نیاز به درمانهای تکمیلی مانند ید رادیواکتیو یا پرتودرمانی کمک کند.
خواندن جواب پاتولوژی تیروئید نیاز به دانش و تجربه پزشکی دارد. جواب پاتولوژی تیروئید معمولا شامل بخشهایی مانند مشخصات بیمار، اطلاعات کلینیکی، روش نمونه برداری، توصیف ماکروسکوپی و میکروسکوپی نمونه، تشخیص پاتولوژیک، و نظر پاتولوژیست است.
پاتولوژی از معده می تواند برای تشخیص و درمان بیماری های مختلف معده مانند زخم، التهاب، پولیپ و سرطان مفید باشد. برای انجام پاتولوژی معده، معمولا نیاز به گرفتن نمونه بافتی از معده با روش آندوسکوپی یا جراحی است.
پاتولوژی پولیپ معده بررسی می کند که پولیپ های معده چه نوعی هستند و چه خطری برای سرطان دارند. پولیپ های معده رشدهای غیرطبیعی از بافت معده هستند که ممکن است علائمی مانند درد، خونریزی و اسهال ایجاد کنند. برخی از پولیپ های معده می توانند بدخیم شوند و به سرطان تبدیل شوند. برای تشخیص پولیپ معده، می توان از آندوسکوپی و بیوپسی استفاده کرد.
پاتولوژی سرطان معده تشخیص می دهد که سرطان معده چه نوعی است و چه مرحله ای از بیماری را دارد. سرطان معده یکی از شایع ترین و کشنده ترین انواع سرطان است که می تواند به عوامل مختلفی مانند عفونت باکتریایی، تغذیه نامناسب، ژنتیک و زخم معده مربوط شود.
پزشکان برای تشخیص این سرطان، میتوانند از روش های مختلفی مانند آندوسکوپی، بیوپسی، سی تی اسکن، اولتراسونوگرافی و آزمایشات خونی استفاده کنند و با خواندن جواب آزمایش پاتولوژی معده درمان مناسب را تجویز کنند.
پاتولوژی قلبی با بررسی نمونههای بافتی یا سلولی از قلب یا عروق، میتوانند علت، نوع و شدت بیماری را مشخص کنند. برخی از بیماریهای قلبی که پاتولوژیستها میتوانند با پاتولوژی قلب و عروق تشخیص دهند عبارتند از:
پاتولوژی کورتاژ تشخیصی یک روش برای بررسی نمونههای بافتی یا سلولی است که از رحم یا دهانه رحم برداشته میشوند. کورتاژ یک عمل جراحی است که در آن پزشک با استفاده از ابزاری به نام کورت، بافتهای داخل رحم را خارج میکند. این عمل میتواند به دلایل مختلفی انجام شود، مانند:
در آزمایش پاتولوژی بعد از کورتاژ به بررسی نمونههای بافتی یا سلولی که از رحم یا دهانه رحم برداشته شده پرداخته میشود. در واقع بعد از این عمل، پاتولوژی جنین سقط شده انجام میشود. آزمایش پاتولوژی جنین میتواند اطلاعات بسیار مهمی ارائه دهد. برای مثال خواندن جواب پاتولوژی جنین میتواند به پزشک و بیمار در درک علت اتمام بارداری، خطرات بارداریهای آینده، تشخیص ناهنجاریهای ساختاری رحم یا دریچههای قلبی، اصلاح روشهای IVF، تاثیرگذاری بر تنظیم خانواده، مشاوره ژنتیک و مراقبتهای بالینی کمک کند.
منظور از پاتولوژی گوارش، بررسی اجزای مختلف این سیستم مهم بدن از جمله روده و معده است که مشکلات این نواحی را بررسی میکند. در ادامه به بررسی دو مورد از این مشکلات میپردازیم:
پولیپ روده یک برآمدگی از لایه مخاطی روده بزرگ است که ممکن است خوش خیم یا بدخیم باشد. برخی از انواع پولیپ ها شامل پولیپ های آدنوماتوز، پولیپ های پلاستیک، پولیپ های گلاندولار و پولیپ های هامارتوماتوز هستند.
پزشکان با خواندن خواندن جواب آزمایش پاتولوژی روده اطلاعات مهمی در مورد نوع، اندازه، تعداد، موقعیت، شکل و درجه تمایز پولیپ به دست میاورند. این اطلاعات می تواند در تعیین ریسک سرطانی شدن پولیپ و روش درمان مناسب کمک کند.
زخم روده یک نقص در لایه مخاطی روده بزرگ است که میتواند به دلایل مختلفی ایجاد شود. برخی از عوامل موثر بر بروز زخم روده شامل عفونت باکتریایی، ویروسی یا قارچی، بیماریهای التهابی روده مانند کولیت اولسراتیو یا بیماری کرون، اختلالات خونی، مصرف برخی داروها مانند آسپرین یا ضد التهاب غیر استروئیدی، ایسکمی یا کاهش خون رسانی به روده و تومورهای خوش خیم یا بدخیم هستند.
خواندن جواب پاتولوژی زخم روده اطلاعاتی در مورد موقعیت، اندازه، شکل، عمق، حاشیه، میزان التهاب، نوع باکتری، وجود نکروز یا آسیب بافتی و وجود تغییرات سلولی غیر طبیعی در اختیار پزشکان قرار میدهد تا برای تعیین بهترین روش درمان بهتر اقدام کنند.
آزمایش پاتولوژی برای بارداری یک روش تشخیصی است که به بررسی بافت ها و سلول های مربوط به بارداری و رحم می پردازد. این آزمایش می تواند به شناسایی علت خونریزی، التهاب، سرطان دهانه رحم، بیماری های ژنتیکی و سایر مشکلات کمک کند. در این ادامه به برخی از انواع آزمایش پاتولوژی برای بارداری اشاره می کنیم:
پاتولوژی رحم شامل برداشتن نمونه از بافت آندومتر (لایه داخلی رحم) یا سرویکس (دهانه رحم) است. این نمونهها در آزمایشگاه زیر میکروسکوپ مورد بررسی قرار میگیرند و میتوانند به تشخیص بیماری هایی مانند سرطان، پولیپ، فیبروم، عفونت و آنومالی های هورمونی کمک کنند. این آزمایش معمولا در صورت داشتن علائمی مانند خونریزی غیرطبیعی، درد لگنی، نازایی یا سقط مکرر انجام می شود.
پولیپ رحم رشد غیرطبیعی و خوش خیم سلول های آندومتر است که به صورت تودههای نرم و کشیده از دهانه رحم بیرون زده یا در داخل حفره رحم قرار می گیرند. این پولیپ ها می توانند باعث خونریزی واژینال، درد، نازایی و سقط جنین شوند. پزشک شما با خواندن جواب پاتولوژی رحم، در صورت تایید وجود پولیپ، معمولا از روش های جراحی مانند هیستروسکوپی یا کورتاژ برای برداشتن آن استفاده می شود.
فیبروم رحم تودههای عضلانی و خوش خیم هستند که در دیواره رحم یا روی آن رشد می کنند. این توده ها میتوانند باعث خونریزی شدید، درد، فشار بر ارگانهای اطراف، تکرر ادرار، یبوست و نازایی شوند و پاتولوژی فیبروم یکی از بهترین روشهای تشخیص این تودهها میباشد. در صورت نیاز به درمان، می توان از روش های دارویی، تزریق یا جراحی برای کاهش یا برداشتن فیبروم استفاده کرد.
شاید بپرسید مهمترین بخش پاتولوژی زنان چیست؛ جواب این سوال پاتولوژی تخمدان و پاتولوژی زگیل تناسلی (HPV) که در پاتولوژی واژن مشخص میشود.
کیست تخمدان کیسه های پر از مایع هستند که در تخمدان یا روی آن ایجاد می شوند. این کیست ها معمولا بدون علائم هستند و در طی چرخه قاعدگی تشکیل و از بین می روند. اما برخی از کیست ها ممکن است بزرگ، پر از خون یا عفونی شوند و باعث درد، خونریزی، تهوع و استفراغ شوند. این کیستها در پاتولوژی تخمدان قابل شناسایی هستند و با جواب آزمایش پاتولوژی کیست تخمدان میتوان راهکار درمانی مناسب را تجویز کرد.
پاتولوژی در آزمایش اسپرم به بررسی شکل، اندازه، تعداد و حرکت اسپرم مردان میپردازد. این آزمایش میتواند علت ناباروری، سقط مکرر یا بیماریهای ژنتیکی را نشان دهد. پاتولوژی اسپرم معمولا با استفاده از میکروسکوپ و روشهای مولکولی انجام میشود. برای انجام این آزمایش، نمونه منی از مرد گرفته شده و برای تحلیل به آزمایشگاه فرستاده خواهد شد.
این آزمایش ساختار و عملکرد جفت را بررسی میکند. جفت عضوی است که جنین را به رحم مادر متصل نموده و مواد مغذی و اکسیژن را به جنین منتقل میکند. پاتولوژی جفت میتواند نشان دهنده ناهنجاریهای جفت باشد که ممکن است عامل سقط، رشد ناکافی جنین، پرهاکلامپسی یا بیماریهای دیگر شوند.
هموروئید یا بواسیر به وضعیتی گفته میشود که در آن وریدهای موجود در ناحیه مقعد و آنال کانال متورم و گسترش می یابند. این وریدها معمولا نقشی در کنترل خروج مدفوع دارند، اما زمانی که فشار زیادی روی آنها وارد شود، ممکن است دردناک، خونریزی و یا بیرون زدگی شوند. پاتولوژی هموروئید شامل بررسی بافتهای برداشته شده از این وریدها توسط یک پاتولوژیست است.
هپاتیت به التهاب کبد گفته می شود که می تواند به دلایل مختلفی از جمله عفونت ویروسی، مصرف الکل، داروها، چربی زیاد در کبد و بیماریهای خودایمنی ایجاد شود. پزشک پاتولوژیست با این بررسی می تواند نوع و میزان آسیب کبدی، علت التهاب، مرحله بیماری و احتمال وجود سیروز یا سرطان را مشخص کند. پزشکان میتوانند با تفسیر آزمایش پاتولوژی کبد این بیماری را مشخص کنند.
پاتولوژی فیستول شاخه ای از پاتولوژی است که به بررسی مجراهای غیرطبیعی بین دو بافت یا اندام مختلف در بدن می پردازد. فیستول ها می توانند در نتیجه عفونت، آسیب، التهاب، بیماری های خاص یا مداخلات جراحی ایجاد شوند و معمولاً با درد، خارج شدن مایعات، خونریزی، عفونت و اختلال در عملکرد اندام ها همراه هستند.
فیستول ها می توانند در هر قسمتی از بدن رخ دهند، اما شایع ترین موارد آنها در ناحیه مقعد، روده، مثانه، واژن، دهان و پوست هستند.
برای تشخیص فیستول ها، معمولاً نیاز به گرفتن نمونه از مجرای فیستول یا بافت های اطراف آن و ارسال آن به آزمایشگاه پاتولوژی داریم. در آزمایشگاه پاتولوژی، پاتولوژیست با استفاده از میکروسکوپ و روش های مختلف رنگ آمیزی، ساختار، نوع و منشأ سلول های فیستول را مورد بررسی قرار می دهد.
همچنین ممکن است از آزمایشهای مکملی مانند ایمونوهیستوشیمی (IHC)، کشت میکروبی، آزمایش های ژنتیکی و مولکولی استفاده شود تا علت، عامل و نوع فیستول را با دقت بیشتری تعیین کند.
گزارش آزمایش پاتولوژی فیستول شامل اطلاعاتی در مورد مکان، اندازه، شکل، جهت، تعداد و نوع مجرای فیستول، نوع و درصد سلول های موجود در آن، وجود یا عدم وجود عفونت، التهاب، نکروز، بدخیمی یا اختلالات دیگر در بافت های فیستول و همچنین تشخیص نهایی و پیشنهاد درمانی می باشد.
پاتولوژی فک و دهان یکی از شاخههای علم پزشکی است که به مطالعه، تشخیص و درمان بیماری ها، آسیب ها و اختلالاتی که مناطق دهان، فک، صورت و گردن را تحت تأثیر قرار می دهند، می پردازد. در ادامه سه نوع از آزمایشات پاتولوژی شایع دهان و دندان را مورد بررسی قرار می دهیم: پاتولوژی کیست دندان، پاتولوژی لثه و پاتولوژی زبان.
کیست دندان یک حفره پر از مایع است که در بافت های نرم یا سخت دهان تشکیل می شود. کیست ها می توانند از عوامل مختلفی مانند عفونت، التهاب، آسیب، بیماری یا اختلالات مادرزادی ناشی شوند. درمان کیست دندان معمولاً شامل جراحی برداشتن کیست و درمان علت آن است.
لثهها می توانند تحت تأثیر بیماری ها و اختلالات مختلفی قرار گیرند که ممکن است به سلامت دندان ها و استخوان فک آسیب برسانند. آزمایش پاتولوژی لثه به تشخیص بهترین درمان کمک میکنند. درمان بیماری های لثه معمولاً شامل بهبود بهداشت دهان و دندان، مسواک زدن، نخ دندان، داروها، جراحی یا درمان لیزری است.
پاتولوژی زبان علم بررسی بیماری های زبان است. زبان یک عضو مهم در دهان است که می تواند توسط عوامل مختلفی آسیب ببیند. برخی از بیماری های شایع زبان عبارتند از: زخم زبان، لیکن پلانوس و گلاسیت. این بیماری ها می توانند باعث درد، خارش، سوزش، تغییر رنگ یا شکل زبان شوند. درمان این بیماری ها بستگی به علت و شدت آنها دارد و ممکن است شامل داروها، جراحی یا درمان لیزری باشد.
کیست مویی یا تریکویلم یک کیسه کوچک پر از مو، چربی و باکتری است که معمولا در ناحیه پشت گردن، شانه، سر یا صورت رشد می کند. این کیست می تواند دردناک، التهابی و یا عفونی شود. پاتولوژی کیست مویی نشان میدهد که کیست از چه نوعی است، چه عواملی در ایجاد آن نقش داشته اند و همچنین احتمال وجود بیماری های دیگر مانند سرطان را بررسی کند.
پاتولوژی خون بخشی از علم پاتولوژی است که به بررسی خون و اندامهای مرتبط با آن میپردازد. پاتولوژی خون علل، علائم و درمان بیماریهای خونی مانند انمی، لوسمی، لنفوم، هموفیلی و ترومبوز را شناسایی میکند. پاتولوژی خون از آزمایشهای مختلفی مانند شمارش کامل خون، آزمایش خونشناسی، آزمایش انعقاد خون و بیوپسی مغز استخوان استفاده میکند.
پاتولوژی گوش به بررسی گوش و بیماریهای آن میپردازد. این آزمایش میتوان علل، علائم و درمان بیماریهای گوشی مانند عفونت گوش میانی، کلستاتوم، تمپانواسکلروز، ناشنوایی، ورتیگو و آکوستیک نوروما را شناسایی میکند.
گوش میانی قسمتی از گوش است که شامل استخوانچهها، ترومپ استاشیوس و مجاورت با مغز است. پاتولوژی گوش بیماریهای این قسمت مانند عفونت گوش میانی، پارگی مزمن پرده گوش، خوردگی استخوانچهها، تمپانواسکلروز و کلستاتوم را شناسایی میکند.
دستگاه اداری نیز یکی از بخشهایی است که میتوان با استفاده از آزمایش پاتولوژی، بخشهای مختلف آن را از جمله مثانه و کلیه را بررسی کرد و مشکلات جدی آنها را شناسایی نمود. برخی از این مشکلات شامل:
سرطان مثانه معمولاً از سلولهایی که سطح داخلی مثانه را پوشش میدهند آغاز میشود و ممکن است به سایر ارگانها گسترش یابد. علائم سرطان مثانه ممکن است شامل خون در ادرار، تکرر ادرار، درد هنگام ادرار و درد در شکم باشد. برای تشخیص سرطان مثانه میتوان از جواب آزمایشات پاتولوژی توده مثانه استفاده نمود.
پاتولوژی سرطان یک روش تشخیصی است که با بررسی ضایعات پاتولوژیک زیر میکروسکوپ انجام میشود. پاتولوژیست میتواند نوع، مرحله و شدت سرطان را مشخص کند و به پزشک در انتخاب روش درمانی مناسب کمک کند. در خصوص اینکه ضایعه پاتولوژیک چیست، باید گفت ضایعه پاتولوژیک به هر تغییر غیرطبیعی در ساختار یا عملکرد یک بافت یا ارگان گفته میشود که ناشی از بیماری یا آسیب است.
پاتولوژی ریه بخشی از علم پاتولوژی است که به بررسی ریه و بیماریهای مربوط به آن میپردازد پاتولوژی ریه علل، علائم و درمان بیماریهای ریوی مانند آسم، برونشیت، آمفیزم، سرطان ریه، توبرکولوز، سیلیکوزیس و آلرژی را شناسایی میکند. پاتولوژی ریه از آزمایشهای مختلفی مانند آزمایش خون، آزمایش تنفسی، برونشوسکوپی، بیوپسی ریه و امآرآی استفاده میکند.
در این آزمایش میتوان مشکلات مختلف کلیهها را بررسی نمود، مثل پاتولوژی سنگ کلیه که برای این بیماری استفاده میشود. پاتولوژیست میتواند علل، علائم و درمان بیماریهای کلیه مانند عفونت کلیه، سنگ کلیه، سیست کلیه، سرطان کلیه، نفروز، گلومرولونفریت و نارسایی کلیه را شناسایی کند.
پاتولوژی طحال برای مطالعه و تشخیص بیماریها و آسیبهایی که طحال را درگیر میکنند. طحال یک عضو لنفاوی است که نقش مهمی در ایمنی بدن و تولید و تخریب گلبولهای خونی دارد. برخی از بیماریهای پاتولوژی طحال عبارتند از: بزرگی طحال، آنمی همولیتیک، لنفوم، لوسمی، انفارکتوس طحال و تومورهای طحال.
پاتولوژی پوست یا درماپاتولوژی به مطالعه و توصیف تغییرات ساختاری و ترکیبی در بیماریهای پوستی میپردازد. پاتولوژی پوست از روشهای میکروسکوپی، ایمونوهیستوشیمی، مولکولی و ژنتیکی برای تشخیص و تفسیر نمونههای بافتی و سلولی پوست استفاده میکند.
پاتولوژی لگن شاخهای از پاتولوژی است که به مطالعه و تشخیص بیماریها و آسیبهایی که ارگانهای لگنی را درگیر میکنند میپردازد. ارگانهای لگنی شامل رحم، تخمدانها، فالوپ، واژن، مثانه، پروستات، بیضهها و کانال اجرایی اسپرم هستند.
این پاتولوژی برای بررسی وضعیت بافت رحم که ممکن است التهاب، خونریزی، فیبروم، پولیپ، سرطان یا بیماری داشته باشد، انجام می شود. در این پاتولوژی، نمونه ای از رحم که در جراحی هیسترکتومی برداشته شده است، تحت میکروسکوپ مورد بررسی قرار می گیرد. این آزمایش پاتولوژی می تواند علت خونریزی غیرطبیعی، نوع و میزان تومور یا سرطان، وجود عفونت یا التهاب یا اختلالات ارثی را مشخص کند.
پاتولوژی چشم به مطالعه و تشخیص بیماریها و آسیبهایی که چشم و اندامهای مرتبط با آن را درگیر میکنند میپردازد. چشم و اندامهای مرتبط با آن شامل کرنیا، لنز، شبکیه، عصب بینایی هستند.
پاتولوژی دیسک کمر بررسی وضعیت بافت های بین مهره ای که ممکن است فشار، التهاب، آسیب یا بیماری داشته باشند، انجام می شود. در این آزمایش، نمونه ای از بافت دیسک کمر با استفاده از سوزن برداشته می شود و تحت میکروسکوپ مورد بررسی قرار می گیرد.
این پاتولوژی لوزه و پاتولوژی لوزه سوم برای شناسایی اختلالات یا بیماری هایی که ممکن است لوزه ها را تحت تاثیر قرار دهند، انجام می شود. این آزمایش می تواند علل خونریزی، التهاب، تورم، تومور، سرطان یا اختلالات ارثی را مشخص کند.
پاتولوژی حنجره به بررسی بیماری ها و آسیب هایی که می توانند حنجره و بافت های اطراف آن را درگیر کنند، می پردازد. حنجره یک ارگان مهم در دستگاه تنفسی و صوتی است که در قسمت بالایی حلق قرار دارد. برخی از علائم این بیماری شامل موارد زیر می باشند:
برخی از بیماری های حنجره عبارتند از: التهاب حنجره، گرفتگی حنجره، پلیپ حنجره، کیست حنجره، پاپیلوم حنجره، سرطان حنجره و متاستاز حنجره.
جواب پاتولوژی حنجره یک گزارش کتبی است که توسط پاتولوژیست تهیه می شود و نتایج بررسی نمونه های بافتی و سلولی حنجره را نشان می دهد. جواب پاتولوژی حنجره می تواند در تشخیص و درمان بیماری های حنجره کمک کننده باشد. جواب پاتولوژی حنجره معمولا شامل اطلاعات زیر است:
پاتولوژی مغز استخوان علمی است که به بررسی ساختار و عملکرد مغز استخوان می پردازد. مغز استخوان یک بافت نرم و قرمزرنگ است که در داخل استخوان ها قرار دارد و نقش مهمی در تولید سلول های خونی دارد. سلول های خونی شامل گلبول های قرمز، گلبول های سفید و پلاکت ها هستند که هر کدام وظایف مختلفی در بدن انجام می دهند.
برخی از بیماری ها و اختلالات می توانند باعث تغییر در ساختار و عملکرد مغز استخوان شوند و منجر به کمبود یا بیش فعالی یا بدخیمی سلول های خونی گردند. برای تشخیص این بیماری ها و اختلالات، ممکن است نیاز باشد که نمونه ای از مغز استخوان از بیمار گرفته شود و تحت آزمایش پاتولوژی قرار گیرد.
آزمایش پاتولوژی مغز استخوان شامل دو روش اصلی است: آسپیراسیون و بیوپسی.
هر دو روش معمولاً با بی حسی موضعی انجام می شوند و ممکن است درد و خونریزی کمی داشته باشند.
نمونه های گرفته شده از مغز استخوان توسط پاتولوژیست زیر میکروسکوپ مورد بررسی قرار می گیرند و گاهی از آزمایش های مکملی مانند ایمونوهیستوشیمی (IHC)، سیتوژنتیک یا فلوسایتومتری استفاده می شود.
تفسیر جواب آزمایش پاتولوژی مغز استخوان بستگی به نوع و هدف آزمایش دارد. معمولاً گزارش آزمایش شامل اطلاعاتی در مورد تعداد و نوع سلول های خونی، درصد سلول های بنیادی، سلول های چربی و بافت های همبند می باشد.
جواب آزمایش پاتولوژی مغز استخوان می تواند نشان دهد که مغز استخوان طبیعی است یا دچار اختلالی مانند کم خونی، لوسمی، لنفوم، مولتیپل میلوما، آمیلوئیدوز، میلوفیبروز، عفونت یا متاستاز سرطانی است. همچنین می تواند اطلاعاتی در مورد شدت و مرحله بیماری ارائه دهد.
در نهایت گزارش آزمایش پاتولوژی مغز استخوان به پزشک کمک می کند تا تشخیص صحیحی از بیماری بدهد و روش درمان مناسب را انتخاب کند.
آزمایش پاتولوژی ژنتیک تشخیص وضعیت ژنتیکی یک فرد، یک بافت یا یک سلول انجام می شود. این پاتولوژی می تواند ناهنجاری های کروموزومی، تغییرات ژنی، اختلالات متابولیک یا بیماری های ژنتیکی را شناسایی کند.
آزمایش پاتولوژی بعد از عمل برای بررسی وضعیت بافت آپاندیس که ممکن است التهاب، عفونت، پارگی یا بیماری داشته باشد، انجام می شود. در این آزمایش، نمونه ای از آپاندیس که در جراحی برداشته شده است، تحت میکروسکوپ مورد بررسی قرار می گیرد. این آزمایش می تواند علت التهاب آپاندیس، نوع باکتری یا عامل عفونی، وجود تومور یا سرطان یا اختلالات ارثی را مشخص کند.
پاتولوژی تومور مغزی به مطالعه و تشخیص تومورهایی که در مغز یا اعصاب جمجمهای رشد میکنند میپردازد. تومورهای مغزی میتوانند از بافتهای مغزی یا از محلهای دیگر بدن به مغز منتشر شوند. تومورهای مغزی میتوانند خوشخیم یا بدخیم باشند و بسته به ماهیت، محل و اندازه آنها علائم و پیامدهای مختلفی داشته باشند.
تومورهای بدخیم به عنوان سرطان شناخته میشوند و میتوانند در هر نقطه از بدن رخ دهند. تومورهای بدخیم معمولا از روشهای میکروسکوپی، ایمونوهیستوشیمی، مولکولی و ژنتیکی شناسایی میشوند و بر اساس درجه تمایز، سرعت رشد، تهاجم و متاستاز طبقهبندی میشوند.
پاتولوژی و سیتولوژی هر از علوم شناخته شده و مهم حوزه پزشکی هستند که بسیاری از افراد به دلیل شباهت واژه پاتولوژی آنها را با یکدیگر اشتباه میگیرند. فرق پاتولوژی و سیتولوژی در این است که:
فرق پاتولوژی با پاتوبیولوژی در این است که:
تفسیر و جواب پاتولوژی عبارتند از توضیح و تحلیل گزارشی که توسط پاتولوژیست در مورد نمونه های بافتی و سلولی که از بدن بیمار گرفته شده اند.
این گزارش می تواند در تشخیص و درمان بیماری های مختلف، به ویژه سرطان ها بسیار مهم باشد. برای خواندن جواب آزمایش پاتولوژی، لازم است که با اصطلاحات و بخش های مختلف آن آشنا شویم. برخی از بخش های اصلی گزارش پاتولوژی عبارتند از:
جواب پاتولوژی می تواند منفی یا مثبت باشد. جواب پاتولوژی منفی به این معنی است که نمونه مورد بررسی هیچ علامتی از بیماری یا اختلالی ندارد و طبیعی است.
جواب پاتولوژی مثبت به این معنی است که نمونه مورد بررسی دارای علامتی از بیماری یا اختلالی است و غیر طبیعی است.
برای مثال، اگر نمونه از یک تومور گرفته شده باشد، جواب پاتولوژی مثبت به این معنی است که تومور سرطانی است و جواب پاتولوژی منفی به این معنی است که تومور خوش خیم است. البته باید توجه داشت که جواب پاتولوژی منفی یا مثبت فقط برای یک نمونه خاص صادق است و نمی تواند برای تمام بدن یا تمام بافت ها قطعی باشد.
بنابراین، ممکن است نیاز به گرفتن نمونه های بیشتر یا انجام آزمایش های دیگر باشد تا تشخیص دقیق تری از وضعیت بیمار داشته باشیم.
هزینه و قیمت آزمایش پاتولوژی بستگی به عوامل مختلفی دارد، مانند نوع و تعداد آزمایش های درخواست شده، آزمایشگاهی که آزمایش را انجام می دهد، مکان و روش نمونه برداری، فوریت و پیچیدگی آزمایش.
وزارت بهداشت هر ساله تعرفه های آزمایش های پاتولوژی را تعیین می کند که معمولاً برای آزمایشگاه های دولتی قیمت کمتری نسبت به آزمایشگاه های خصوصی تعیین میشود است. البته برخی آزمایشگاه ها ممکن است هزینه های اضافی برای خدمات خاصی ارائه تعیین.
هزینه متوسط یک آزمایش پاتولوژی در ایران از ۵۰ هزار تومان تا ۶۰۰ هزار تومان متغیر است. شما می توانید با پزشک یا کارکنان آزمایشگاه مشورت کنید تا برآورد دقیقی از هزینه و قیمت آزمایش پاتولوژی خود بدست آورید.
اصطلاحات آزمایش پاتولوژی مجموعه ای از واژه ها، عبارت ها و اختصارات است که پاتولوژیست ها برای توصیف و تشخیص بیماری ها و اختلالات بافتی و سلولی استفاده می کنند. این اصطلاحات معمولاً بر اساس معیارهایی چون مورفولوژی، فیزیولوژی، بیوشیمی، ایمونولوژی، ژنتیک و مولکولی تعریف می شوند و به پزشکان و بیماران کمک می کنند تا نتایج آزمایش های پاتولوژی را بهتر درک و تفسیر کنند.
برخی از اصطلاحات آزمایش پاتولوژی عبارتند از:
کتاب پاتولوژی رابینز یکی از معتبرترین و محبوب ترین کتاب های آموزشی در رشته پاتولوژی است که توسط گروهی از پاتولوژیست های مشهور نوشته شده است. این کتاب در دو نسخه پایه و کامل منتشر شده است.
کتاب پاتولوژی رابینز با استفاده از تصاویر، نمودارها، جداول و مثال های بالینی، مفاهیم پاتولوژی را به زبانی ساده و روان بیان می کند و همچنین از آخرین دستاوردهای علمی و پژوهشی در زمینه پاتولوژی استفاده می کند و به روزرسانی می شود.